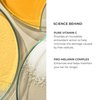
Natura Bissé C+C Vitamin Summer Lotion | Vitamin C Color Enhancing Body Lotion | Hydrates, Soothes & Enhances Sun Tan | For normal & dry skin, 7 Oz

Natura Bissé C+C Vitamin Summer Lotion | Vitamin C Color Enhancing Body Lotion | Hydrates, Soothes & Enhances Sun Tan | For normal & dry skin, 7 Oz
- Intense Hydration: Provides deep moisture to soothe and hydrate skin, especially after sun exposure
- Aloe Vera Enriched: Infused with aloe vera for its calming and moisturizing benefits on dry, irritated skin
- Antioxidant Rich: Packed with antioxidants to fight free radical damage and slow down the aging process
- Vitamin C Boost: Contains Vitamin C to enhance skin protection and fade dark spots
- Lightweight Formula: Non-greasy and quickly absorbed, perfect for face and body
- Color: Beige
- Manufacturer: Natura Bissé
- Model Number: 32A229
- Package Quantity: 1
- Part Number: 32A229
- Size: 1 Count (Pack of 1)
Natura Bissé C+C Vitamin Summer Lotion | Vitamin C Color Enhancing Body Lotion | Hydrates, Soothes & Enhances Sun Tan | For normal & dry skin, 7 Oz
Shipping Summary:
We currently ship exclusively to addresses within the Canada.
Standard International Shipping from the United States to Canada costs CAD 14.99.
Shipping Time & Methods
Estimated Delivery Time: 10–15 business days
This total includes both processing and transit times.
-
Processing Time: All orders are processed and dispatched within 1–3 business days of purchase.
-
International Transit (US to Canada):
Orders are initially shipped via FedEx from our U.S.-based fulfillment centers.
Average international transit time is 4–8 business days. -
Domestic Delivery within Canada:
Once the shipment arrives in Canada, it is handed over to Canada Post or UPS for final delivery.
Canada domestic delivery typically takes an additional 2–4 business days.
Shipping times may vary depending on the product’s fulfillment center and any customs processing that may be required.
Please note that while most packages arrive within the estimated timeframe, unexpected delays may occur due to factors such as customs inspections, public holidays, weather disruptions, or other unforeseen circumstances. Delivery dates are not guaranteed, as final transportation is managed by third-party carriers.
Tracking Information
You will receive a tracking number via email once your order has been dispatched.
Products may be shipped from different fulfillment centers depending on availability and inventory levels.
Delivery Information
Orders are delivered directly to most addresses within Canada, with the exception of P.O. boxes.
In certain remote or rural areas, additional delivery fees may apply. In such cases, you may be required to collect your parcel from the nearest shipping partner’s location.
Overview
We want you to be satisfied with your purchase. Please review our refund and return policy to understand how to proceed if you need to return an item or request a refund.
Order Cancellations
Canceling Your Order Before Shipping:
You can cancel your order within 2 hours of placing it. To do so:
-
Log in to your account and cancel the order directly.
-
Alternatively, email us immediately at cs@everymarket.ca with your order details.
If More Than 2 Hours Have Passed:
If it's been more than 2 hours since you placed your order, you will need to contact our customer service team for assistance. Please email us at cs@everymarket.ca with your order details.
Once Your Order Has Shipped:
Unfortunately, we cannot cancel orders once they’ve been shipped. In that case, you can return the item by following our return process.
Return Policy
Return Period: You have 30 days from the date of delivery to request a return.
Item Condition: Products must be unused, unwashed, and in their original packaging with all tags attached.
Return Shipping Costs: Customers are responsible for return shipping fees unless the item is defective.
Return Approval: Returns must be approved before sending items back. Contact us at cs@everymarket.ca to begin the process.
How to Initiate a Return
-
Contact our support team at cs@everymarket.ca with your order number and reason for the return.
-
If approved, we will provide a return shipping label and detailed instructions.
-
Pack the item securely and send it back using a trackable shipping method.
-
Once received and inspected, we will process your refund or exchange.
Defective or Damaged Products
If you receive a defective, damaged, or incorrect item, please contact us immediately.
Return Eligibility: Used defective items may be returned if the defect is confirmed.
Shipping Costs: We will cover the return shipping cost for defective or incorrect items.
Refund: A full refund, including original shipping costs, will be issued for defective items.
Returns for Customer Remorse (Changed Mind, Wrong Item Ordered)
Eligibility: Items may be returned within 30 days if they are unused and in their original condition.
Shipping Costs: Customers are responsible for return shipping fees.
Refund: Original shipping costs are non-refundable for remorse-based returns.
Items Not Eligible for Return
-
Electronic devices after 30 days (e.g., laptops, tablets, Kindles)
-
Gift cards and prepaid game cards
-
Perishable goods, some jewelry, and personal care items
-
Customized or personalized products
-
Items with special shipping restrictions
Refund Process
Processing Time: Refunds are issued within 3-5 business days after we receive and inspect the returned item.
Refund Method: Refunds are credited to the original payment method or as store credit for purchases made with gift cards.
Bank Processing: Please allow additional time for your bank to process the refund.
Exchanges
To exchange an item quickly, return the original product and place a new order for the replacement.
Return Address
EveryMarket Customer Service
Address: 46 Darnborough Way, City: Scarborough, Province: Ontario, Post code: M1W 2G1
Customer Support
Our support team is available 24/7 for any questions or assistance.
📧 Email: cs@everymarket.ca
- Intense Hydration: Provides deep moisture to soothe and hydrate skin, especially after sun exposure
- Aloe Vera Enriched: Infused with aloe vera for its calming and moisturizing benefits on dry, irritated skin
- Antioxidant Rich: Packed with antioxidants to fight free radical damage and slow down the aging process
- Vitamin C Boost: Contains Vitamin C to enhance skin protection and fade dark spots
- Lightweight Formula: Non-greasy and quickly absorbed, perfect for face and body
- Color: Beige
- Manufacturer: Natura Bissé
- Model Number: 32A229
- Package Quantity: 1
- Part Number: 32A229
- Size: 1 Count (Pack of 1)
Natura Bissé C+C Vitamin Summer Lotion | Vitamin C Color Enhancing Body Lotion | Hydrates, Soothes & Enhances Sun Tan | For normal & dry skin, 7 Oz
Shipping Summary:
We currently ship exclusively to addresses within the Canada.
Standard International Shipping from the United States to Canada costs CAD 14.99.
Shipping Time & Methods
Estimated Delivery Time: 10–15 business days
This total includes both processing and transit times.
-
Processing Time: All orders are processed and dispatched within 1–3 business days of purchase.
-
International Transit (US to Canada):
Orders are initially shipped via FedEx from our U.S.-based fulfillment centers.
Average international transit time is 4–8 business days. -
Domestic Delivery within Canada:
Once the shipment arrives in Canada, it is handed over to Canada Post or UPS for final delivery.
Canada domestic delivery typically takes an additional 2–4 business days.
Shipping times may vary depending on the product’s fulfillment center and any customs processing that may be required.
Please note that while most packages arrive within the estimated timeframe, unexpected delays may occur due to factors such as customs inspections, public holidays, weather disruptions, or other unforeseen circumstances. Delivery dates are not guaranteed, as final transportation is managed by third-party carriers.
Tracking Information
You will receive a tracking number via email once your order has been dispatched.
Products may be shipped from different fulfillment centers depending on availability and inventory levels.
Delivery Information
Orders are delivered directly to most addresses within Canada, with the exception of P.O. boxes.
In certain remote or rural areas, additional delivery fees may apply. In such cases, you may be required to collect your parcel from the nearest shipping partner’s location.
Overview
We want you to be satisfied with your purchase. Please review our refund and return policy to understand how to proceed if you need to return an item or request a refund.
Order Cancellations
Canceling Your Order Before Shipping:
You can cancel your order within 2 hours of placing it. To do so:
-
Log in to your account and cancel the order directly.
-
Alternatively, email us immediately at cs@everymarket.ca with your order details.
If More Than 2 Hours Have Passed:
If it's been more than 2 hours since you placed your order, you will need to contact our customer service team for assistance. Please email us at cs@everymarket.ca with your order details.
Once Your Order Has Shipped:
Unfortunately, we cannot cancel orders once they’ve been shipped. In that case, you can return the item by following our return process.
Return Policy
Return Period: You have 30 days from the date of delivery to request a return.
Item Condition: Products must be unused, unwashed, and in their original packaging with all tags attached.
Return Shipping Costs: Customers are responsible for return shipping fees unless the item is defective.
Return Approval: Returns must be approved before sending items back. Contact us at cs@everymarket.ca to begin the process.
How to Initiate a Return
-
Contact our support team at cs@everymarket.ca with your order number and reason for the return.
-
If approved, we will provide a return shipping label and detailed instructions.
-
Pack the item securely and send it back using a trackable shipping method.
-
Once received and inspected, we will process your refund or exchange.
Defective or Damaged Products
If you receive a defective, damaged, or incorrect item, please contact us immediately.
Return Eligibility: Used defective items may be returned if the defect is confirmed.
Shipping Costs: We will cover the return shipping cost for defective or incorrect items.
Refund: A full refund, including original shipping costs, will be issued for defective items.
Returns for Customer Remorse (Changed Mind, Wrong Item Ordered)
Eligibility: Items may be returned within 30 days if they are unused and in their original condition.
Shipping Costs: Customers are responsible for return shipping fees.
Refund: Original shipping costs are non-refundable for remorse-based returns.
Items Not Eligible for Return
-
Electronic devices after 30 days (e.g., laptops, tablets, Kindles)
-
Gift cards and prepaid game cards
-
Perishable goods, some jewelry, and personal care items
-
Customized or personalized products
-
Items with special shipping restrictions
Refund Process
Processing Time: Refunds are issued within 3-5 business days after we receive and inspect the returned item.
Refund Method: Refunds are credited to the original payment method or as store credit for purchases made with gift cards.
Bank Processing: Please allow additional time for your bank to process the refund.
Exchanges
To exchange an item quickly, return the original product and place a new order for the replacement.
Return Address
EveryMarket Customer Service
Address: 46 Darnborough Way, City: Scarborough, Province: Ontario, Post code: M1W 2G1
Customer Support
Our support team is available 24/7 for any questions or assistance.
📧 Email: cs@everymarket.ca
Oops!
Sorry, it looks like some products are not available in selected quantity.